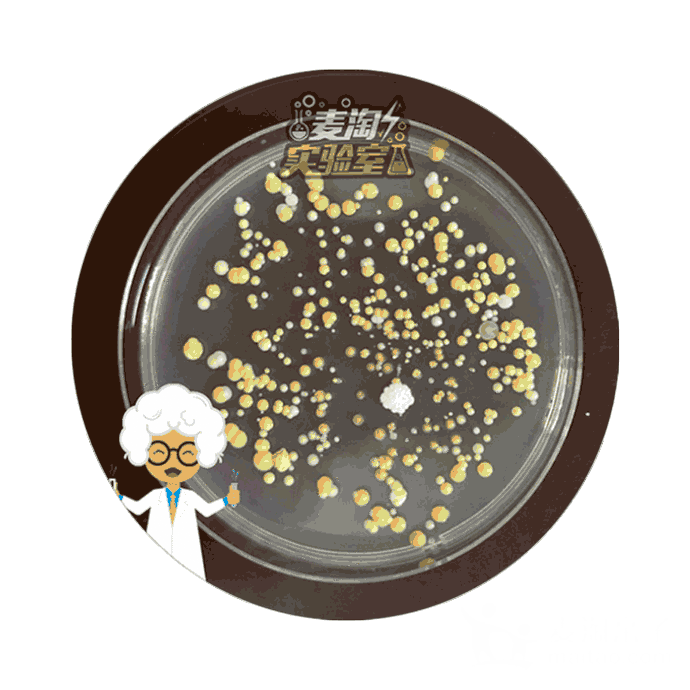
麦淘的神奇宝盒,可以让小朋友不用显微镜,就能让手指上隐身着的细菌"

显微镜下的细菌动图

显微镜下的自来水▼这些新闻都告诉我们,一定要勤洗手,给周围消毒!
图片尺寸328x184
博士养群细菌当"宠物"玩赚了6000万
图片尺寸640x480
抗旱和抗寒能力都会大幅提升,植物还能增强免疫力,在微生物的帮助下
图片尺寸390x224
在显微镜下,母乳是活的,大一些的泡泡是脂肪球,而那些萌萌哒动来动去
图片尺寸336x280
显微镜下显示靶向杀菌,迅速消灭脚上潜伏的真菌,细菌涂抹在脚上
图片尺寸640x320
显微取精手术是在显微镜下进行的微创手术,对睾丸和血管的损伤非常小
图片尺寸320x240
显微镜下白细胞攻击细菌图 大开眼界!
图片尺寸280x280
claus grimm,澳大利亚放大倍数:10x, 40x△颤藻(一种丝状蓝细菌属
图片尺寸480x270
可以放大2000倍的纸片显微镜成本不到2元下一个某宝爆款
图片尺寸400x294
908听友福利社国货推荐丨只有巴掌大小的显微镜却能放大60120倍随时
图片尺寸640x480
自然子刊科学家首次拍到细菌用长长秀发抢dna的瞬间科学大发现
图片尺寸302x308
麦淘的神奇宝盒,可以让小朋友不用显微镜,就能让手指上隐身着的细菌"
图片尺寸690x690
的研究可当大隅将酵母细胞放在显微镜下面的时候他意识到了一个很大
图片尺寸398x240
这样洗奶瓶宝宝直接吃细菌细思极恐
图片尺寸640x566
此时,将面包放到显微镜下观察, 会发现菌群的微观世界挺奇妙的.
图片尺寸500x229
不计可数的纤毛在进行规律的上下摆动,阻挡着我们吸入的粉尘,细菌杂质
图片尺寸428x329
不要小看单细胞的细菌,它们可能真的拥有"智慧"
图片尺寸480x320
神秘的细菌内部结构有铁轨有马蹄还有座迷你埃菲尔铁塔
图片尺寸478x266
科学家在显微镜底下观察了青霉素对细菌的杀伤作用
图片尺寸488x324
惊显微镜下的根结线虫原来长这样高清组图让你全面了解这货的前世今生
图片尺寸280x208